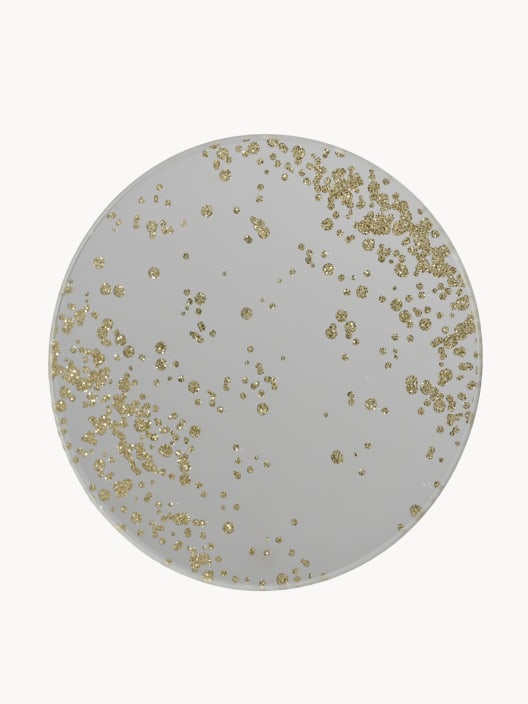
Bandeja portavelas cristal purpurina plata Ø10 cm

Bandeja portavelas cristal purpurina plata Ø10 cm
Club Fronda
(1 opiniones)
Compra mínima unidades.
Más información
Más información
Producto agotado. ¿Te avisamos?
Escribe tu dirección de correo electrónico y te avisaremos cuando volvamos a tenerlo disponible. (No usaremos tu email para nada más)
El formato del correo electrónico no es válido.
¡Listo!
Si tu producto vuelve a estar disponible, te enviaremos un correo electrónico a
Producto voluminoso.
Gasto de envío: por unidad.
1
Paga en 3 plazos de
sin intereses con

Acumula puntos y descuentos exclusivos del
Club Fronda
Envío gratis a partir de 70 €*
Devoluciones hasta 30 días
Recogida en tienda gratis
Especies variadas. Se enviará según disponibilidad.
Esta planta se cultiva en diferentes especies o variedades. Si nos indicas tu preferencia en el campo de observaciones al finalizar tu pedido, haremos lo posible por enviártela.
Color de las hojas sujeto a disponibilidad
Esta planta se cultiva con las hojas de distintos colores, y no se puede elegir. Puedes indicarnos tu preferencia en el campo de observaciones al finalizar tu pedido, haremos lo posible por seleccionarlas pero no podemos garantizarlo.
Color de la flor sujeto a disponibilidad.
Esta planta se cultiva con las flores en distintos colores, y no se puede elegir. Puedes indicarnos tu preferencia en el campo de observaciones al finalizar tu pedido, haremos lo posible por seleccionarlas pero no podemos garantizarlo.
Color de los frutos sujeto a disponibilidad
Esta planta se cultiva con frutos de distintos colores. Si nos indicas tu preferencia de color en el campo de observaciones al finalizar tu pedido, haremos lo posible por enviártela.
Se enviará una sola unidad (según disponibilidad)
En este producto, el modelo exacto no se puede seleccionar, pero puedes indicar tu preferencia en el campo de observaciones al finalizar tu pedido.
Descripción
Bandeja redonda de cristal con purpurina plateada, ideal como base para velas y pequeños centros navideños.
Más información
Ø10×0,3 cm
Categorías
Número de artículo:
¿Te ha resultado útil la información de este producto?
Valoración
4.0
Basado en 1 opiniones
Sin datos
Sobre unidades vendidas online de este producto
100%
De los clientes recomiendan este producto
¿Cómo calculamos esta nota?
Utilizamos la plataforma externa independiente Trustpilot para pedir a nuestros clientes que valoren su experiencia de compra y la relación calidad/precio de cada uno de los artículos que compran.
La nota mostrada se obtiene calculando la media de las valoraciones de cada una de las tallas o tamaños. Puedes verlo en detalle en el bloque de “Opiniones de clientes por artículo”.
Consideramos como recomendación las valoraciones de clientes a partir de 4.0
Opiniones de clientes por artículo
Nº de artículo: 11261865
Bandeja portavelas cristal purpurina plata Ø10 cm
4.0
Compra mínima
¿Por qué este producto requiere un mínimo de compra?
Cuidamos cada detalle para que tus plantas lleguen en perfectas condiciones. Por eso, en algunos productos como este, establecemos una cantidad mínima de compra que nos permite optimizar el envío y el servicio.
♻️
Reducimos el impacto ambiental
Al agrupar varias unidades, reducimos residuos de embalaje y emisiones de CO₂.
Al agrupar varias unidades, reducimos residuos de embalaje y emisiones de CO₂.
🙂
Mantenemos precios competitivos
Repartir el coste de envío entre más plantas abarata el importe final por unidad.
Repartir el coste de envío entre más plantas abarata el importe final por unidad.
📦
Aseguramos una entrega de calidad
Al unificar varias unidades en un pedido, aplicamos un sistema de embalaje especializado y reducimos la manipulación, minimizando posibles daños y garantizando que cada planta llegue en óptimas condiciones.
Al unificar varias unidades en un pedido, aplicamos un sistema de embalaje especializado y reducimos la manipulación, minimizando posibles daños y garantizando que cada planta llegue en óptimas condiciones.